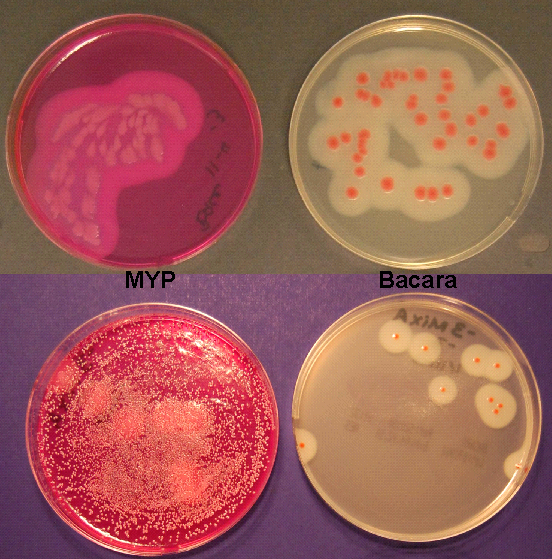
- Colonies of B. cereus on MYP and Bacara agar medium (Imagesource)

There are two medically important Bacillusspecies: Bacillus anthraciswhich causes anthrax, and *Bacillus cereus,*which causes a foodborne illness (food poisoning) similar to that of Staphylococcus.

Gram Staining
Gram-positive rods often arranged in pairs or chains with rounded or square ends and usually have a single endospore. Endospore is generally oval or sometimes round or cylindrical and is very resistant to adverse conditions.
Cultural Characteristics
MYP agar or chromogenic agar named Bacara is used to isolate B. cereus from food sample. MYP agar is comparatively less selective (which may create problems for the recovery of the target organism but inhibits the growth of background flora) compared to Bacara, which is both selective and differential agar and some scientist/researchers have suggested using this chromogenic agar for the enumeration of B. cereusgroup as a substitute for MYP.
After 18-24 hr incubation at 30°C B. cereuscolonies are usually a pink-orange color on Bacara or pink on MYP and may become more intense after additional incubation. These colonies are surrounded by a precipitate zone, which indicates that lecithinase is produced.
Biochemical Characteristics
Biochemical testing is necessary to identify the organism up to the species level. Following biochemical characteristics help to identify B. cereus from other species of Bacillus.
- Inability to produce acid from mannitol.
- Production of lecithinase.(These two properties (1 &2) differentiates B. cereus group from all other aerobic endospore-forming bacteria)
- Bacillus cereus is usually motile by peritrichous flagella. A few B. cereusstrains are non-motile.
- They are aerobic or facultatively anaerobic.
- B. cereus cultures usually are strongly hemolytic and produce 2-4 mm zone of complete (β) hemolysis surrounding growth. This characteristic helps in differentiating B. cereus from B. anthraciswhich is non-hemolytic.
- They are usually catalase-positive.
- They can utilize carbohydrate anaerobically (i.e., carbohydrate fermentation reaction positive)
- Most species are oxidase-positive, which may lead to confusion with Pseudomonasspecies, especially if the Bacillusspecies are poorly stained.
- B. cereus does not produce rhizoid colonies or protein toxin crystals.
Habitatand Transmission
Soil is the reservoir of this organism, where it adopts a saprophytic life cycle; germinating, growing, and sporulating in this environment. It is also found in a variety of foods such as rice grains, potato, pasta, beans, vegetables, turkey, beef, etc.
Spore survive normal cooking temperature during the preparation of rice. The spores germinate when rice is kept warm for many hours (e.g., reheated fried rice). The portal of entry is the gastrointestinal tract.

Disease andPathogenesis
Bacillus cereusproduces two enterotoxins, emetic (vomiting) and diarrheal – causing two types of illness.
Emetic syndrome
The emetic syndrome is an intoxication caused by ingestion of a cyclic peptide toxin called cereulidethat is pre-formed in the food during the growth of B. cereus. The mode of action of cereulide toxin resembles that of staphylococcal enterotoxin (i.e., it is a superantigen).
Emetic syndrome has a short incubation period (2-4 hours) and consists primarily of nausea and vomiting, and abdominal cramping, similar to staphylococcal food poisoning. Recovery usually occurs within 6–24 hours.
Diarrheal syndrome
The diarrheal syndrome is caused by enterotoxins produced by B. cereus inside the host (i.e. infection). The mode of action of this enterotoxin is the same as that of cholera toxin (i.e., it causes ADP-ribosylation of G protein, which stimulates adenylate cyclase and leads to an increased concentration of cyclic AMP within the enterocytes).
The incubation period is long; 12-18 hours and the illness usually lasts for 1-2 days, although it can continue for several days. Symptoms are usually mild with abdominal cramps, watery diarrhea, and nausea resembling clostridial gastroenteritis.
Laboratory Diagnosis
Diagnosis is clinical. Laboratory diagnosis is not usually done.
Routine examination of foods is done to rule out possible contamination with Bacillus cereus. Gram-staining, colony characteristics on BYP agar or Bacara chromogenic media, and biochemical tests mentioned above are taking into accounts for the identification.
Treatment
Only symptomatic treatment or supportive care is given which includes fluids, electrolytes, etc.
Prevention
There are no specific means of prevention. Vaccine is not available. Rice should not be kept warm for long periods.
References and further readings
- McDowell RH, Sands EM, Friedman H. Bacillus cereus. [Updated 2020 Sep 11]. In: StatPearls [Internet]. Treasure Island (FL): StatPearls Publishing; 2021 Jan-. Available from: https://www.ncbi.nlm.nih.gov/books/NBK459121/
- Bacteriological Analytical Manual, Bacillus cereus. U.S. Food & Drug Administration.
- Per Einar Granum, Terje Lund, Bacillus cereus and its food poisoning toxins, FEMS Microbiology Letters, Volume 157, Issue 2, December 1997, Pages 223–228, https://doi.org/10.1111/j.1574-6968.1997.tb12776.x
- Bacillus cereus, BC Center for Disease Control.
- Image sources: University of Copenhagen – Denmark, Biomerieux,